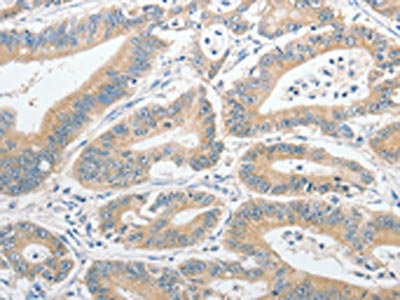

UCHL5 Antibody
-
中文名稱:UCHL5兔多克隆抗體
-
貨號(hào):CSB-PA195221
-
規(guī)格:¥1100
-
圖片:
-
The image on the left is immunohistochemistry of paraffin-embedded Human thyroid cancer tissue using CSB-PA195221(UCHL5 Antibody) at dilution 1/20, on the right is treated with fusion protein. (Original magnification: ×200)
-
The image on the left is immunohistochemistry of paraffin-embedded Human colon cancer tissue using CSB-PA195221(UCHL5 Antibody) at dilution 1/20, on the right is treated with fusion protein. (Original magnification: ×200)
-
-
其他:
產(chǎn)品詳情
-
Uniprot No.:
-
基因名:UCHL5
-
別名:UCH37 antibody; AD-019 antibody; CGI 70 antibody; INO80 complex subunit R antibody; INO80R antibody; Ubiquitin C terminal hydrolase L5 antibody; Ubiquitin C terminal hydrolase UCH37 antibody; Ubiquitin C-terminal hydrolase UCH37 antibody; Ubiquitin carboxyl terminal esterase L5 antibody; Ubiquitin carboxyl terminal hydrolase isozyme L5 antibody; Ubiquitin carboxyl terminal hydrolase L5 antibody; Ubiquitin carboxyl-terminal hydrolase isozyme L5 antibody; Ubiquitin thioesterase L5 antibody; Ubiquitin thiolesterase L5 antibody; UCH L5 antibody; UCH-L5 antibody; UCHL5 antibody; UCHL5_HUMAN antibody
-
宿主:Rabbit
-
反應(yīng)種屬:Human,Mouse
-
免疫原:Fusion protein of Human UCHL5
-
免疫原種屬:Homo sapiens (Human)
-
標(biāo)記方式:Non-conjugated
-
抗體亞型:IgG
-
純化方式:Antigen affinity purification
-
濃度:It differs from different batches. Please contact us to confirm it.
-
保存緩沖液:-20°C, pH7.4 PBS, 0.05% NaN3, 40% Glycerol
-
產(chǎn)品提供形式:Liquid
-
應(yīng)用范圍:ELISA,IHC
-
推薦稀釋比:
Application Recommended Dilution ELISA 1:2000-1:5000 IHC 1:25-1:100 -
Protocols:
-
儲(chǔ)存條件:Upon receipt, store at -20°C or -80°C. Avoid repeated freeze.
-
貨期:Basically, we can dispatch the products out in 1-3 working days after receiving your orders. Delivery time maybe differs from different purchasing way or location, please kindly consult your local distributors for specific delivery time.
-
用途:For Research Use Only. Not for use in diagnostic or therapeutic procedures.
相關(guān)產(chǎn)品
靶點(diǎn)詳情
-
功能:Protease that specifically cleaves 'Lys-48'-linked polyubiquitin chains. Deubiquitinating enzyme associated with the 19S regulatory subunit of the 26S proteasome. Putative regulatory component of the INO80 complex; however is inactive in the INO80 complex and is activated by a transient interaction of the INO80 complex with the proteasome via ADRM1.
-
基因功能參考文獻(xiàn):
- Our study provides a new mechanism for chromatin occupancy of Tcf7 and uncovers the physiological significance of Uch37 during early vertebrate development by regulating the Wnt/beta-catenin pathway. PMID: 28198400
- Our studies provide a molecular mechanism by which UCHL5 mitigates TGFbeta-1 signaling by stabilizing Smad2/Smad3. These data indicate that UCHL5 may contribute to the pathogenesis of idiopathic pulmonary fibrosis and may be a potential therapeutic target. PMID: 27604640
- Positive cytoplasmic UCHL5 tumor immunoexpression is linked to increased survival of patients with small (<5 cm) tumors (p = 0.001), disease stages I-II (p = 0.025), and age 66 years or older (p = 0.037). UCHL5 is thus a potential marker in gastric cancer with new prognostic relevance. PMID: 29474458
- our report demonstrates significant value in targeting USP14/UCHL5 with VLX1570 in drug-resistant Waldenstrom macroglobulinemia (WM) and carries a high potential for clinical translation PMID: 27813535
- UCHL5 is a promising novel prognostic marker in lymph-node-positive rectal cancer. Our results also advance the currently limited knowledge of biomarkers in colorectal cancer treatment. PMID: 28681694
- UCHL5 expression could function as a prognostic marker in pancreatic ductal adenocarcinoma, particularly at disease stages IIB to III. As UCHL5 is one of the few markers predicting increased survival, our results may be of clinical relevance. PMID: 28653876
- These results uncover a novel mechanism for E2F1 transcriptional activation through removal of its Lys-63-linked ubiquitination by UCH37. PMID: 26396186
- Uch37 consists of two domains, a globular UCH-domain and a fibrous C-terminal tail. The C-terminal residues of Uch37 are implicated in Rpn13 binding. PMID: 21953935
- Data indicate that ubiquitin thioesterase L5 UCH37 (UCHL5) comprises a catalytic UCH domain followed by the four-helix (alpha8-alpha11) C-terminal domain. PMID: 25702872
- High expression of UCH37 is significantly associated with epithelial ovarian cancer. PMID: 25123264
- b-AP15 is an inhibitor of deubiquitylating enzyme USP14 and UCHL5 induces apoptosis in multiple myeloma and overcomes bortezomib resistance. PMID: 24319254
- UCH37 over-expression is associated with hepatocellular carcinoma recurrence. PMID: 23220010
- UCH37 is associated with outcome and recurrence of ESCC and can be a novel predictor for poor prognosis of esophageal squamous cell carcinoma patients after curative resection. PMID: 22615012
- a functional proteomic analysis was performed to screen UCH37-interacting proteins in hepatocellular carcinoma (HCC), and glucose-regulated protein 78 was identified as one interacting with UCH37 PMID: 21800051
- our structures reveal conformationally dynamic parts of the enzyme that may play a role in the structural transition to the more active form. PMID: 21995438
- Silencing of UCH37 in A549 cells induced apoptosis. PMID: 21287580
- UCH37 interacts with Smads and regulates TGF-beta signalling. PMID: 16027725
- Upregulation of UCH37 is associated with Uterine Cervical Neoplasms PMID: 16402389
- In the nucleus Uch37 is also associated with the human Ino80 chromatin-remodeling complex (hINO80). PMID: 18922472
- the crystal structure of the UCH37 catalytic domain (UCH-domain) was determined and compared with that of the other UCHs. PMID: 19836345
顯示更多
收起更多
-
亞細(xì)胞定位:Cytoplasm. Nucleus. Note=Associates with the proteasome 19S subunit in the cytoplasm. Associates with the INO80 complex in the nucleus.
-
蛋白家族:Peptidase C12 family
-
數(shù)據(jù)庫鏈接:
Most popular with customers
-
-
YWHAB Recombinant Monoclonal Antibody
Applications: ELISA, WB, IHC, IF, FC
Species Reactivity: Human, Mouse, Rat
-
Phospho-YAP1 (S127) Recombinant Monoclonal Antibody
Applications: ELISA, WB, IHC
Species Reactivity: Human
-
-
-
-
-